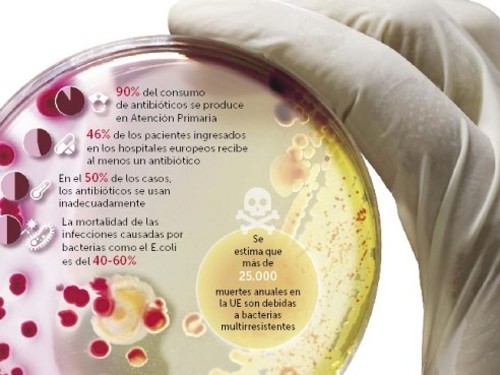

CATEGORÍA: Farmacia
Los antibióticos ya no pueden con la salmonela
23 febrero 2017
La UE asegura que la amenaza de las bacterias es «alarmante». Un nuevo informe revela más formas de resistencia a antibióticos como los que luchan contra la salmonelosis, la segunda enfermedad alimentaria más frecuente.
La Comunitat Valenciana se incorpora a la receta electrónica interoperable del Sistema Nacional de Salud
23 febrero 2017
Sólo con presentar la tarjeta SIP en la oficina de farmacia se podrá recoger la medicación necesaria, independientemente de la comunidad de prescripción, de entre las interoperables. De esta forma se evita el consumo de recursos sanitarios y la generación de inconvenientes a la ciudadanía en sus desplazamientos
El Peset y La Fe prueban un fármaco para retrasar la aparición del alzhéimer
20 febrero 2017
Los equipos investigadores recurren a anuncios en prensa para reclutar a voluntarios, ya que el estudio se hace sobre personas con riesgo pero sin ningún tipo de síntoma
Sanidad suspende la vacunación del tétanos a los 14 años por falta de dosis
20 febrero 2017
La conselleria reserva los inyectables para pacientes con riesgo
Yolanda Barcina ingresa en la Real Academia de Farmacia
20 febrero 2017
La ex presidenta de Navarra, catedrática de Nutrición y Bromatología, defendió en su discurso un modelo sostenible de desarrollo

Farmacias abiertas y de urgencia más cercanas
Farmacias abiertas y de urgencia más cercanas